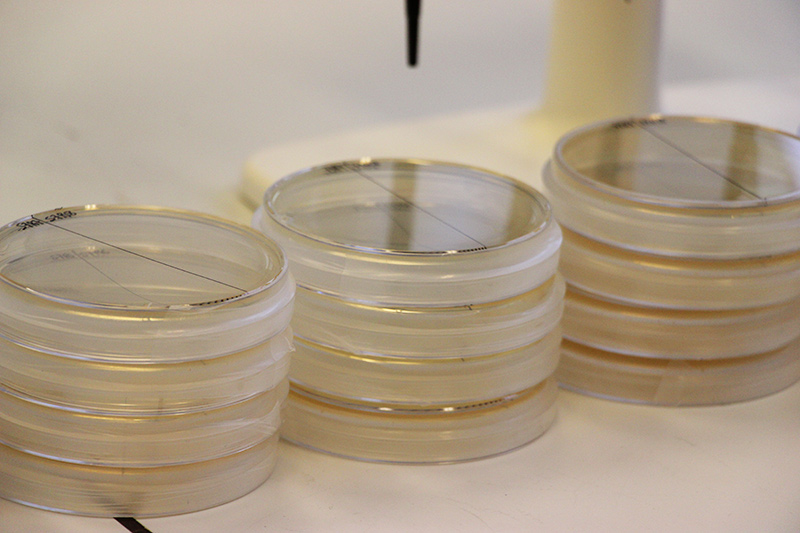

BIOTECHNOLOGIES
L’isolement, l’étude, la valorisation et la production des microorganismes sont le cœur de métier de Leo viridis. Nos compétences et nos équipements nous permettent de vous proposer une large gamme de services et de solutions pour vous aider à résoudre vos problématiques.
Nos savoirs-faire :
- Isolement et culture de microorganismes extrêmophiles et fastidieux (ex SRB, archaea, phages)
- Conception de nouveaux bioprocédés (ex réacteur de biolixiviation)
- Recherches d’alternatives aux biocides et écocides chimiques traditionnels